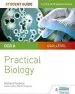
Audiobook Ocr A-Level Biology Student Guide: Practical Biology author Richard Fosbery

The Piano Practice Physician'S Handbook: 32 Common Piano Student Ailments and how Piano Teachers can Cure Them for Good [Audiobook] download free by Nicola Cantan

- Listen audiobook: The Piano Practice Physician'S Handbook: 32 Common Piano Student Ailments and how Piano Teachers can Cure Them for Good
- Author: Nicola Cantan
- Release date: 2017/9/10
- Publisher: COLOURFUL KEYS
- Language: English
- Genre or Collection: Teaching Resources and Education
- ISBN: 9781527207004
- Rating: 8.55 of 10
- Votes: 370
- Review by: Koda Bonner
- Review rating: 7.21 of 10
- Review Date: 2018/9/7
- Duration: 1H51M20S in 256 kbps (29.6 MB)
- Date of creation of the audiobook: 2018-09-01
- You can listen to this audiobook in formats: MPEG4, FLAC, MP3, WAV, WMA, MPEG-4 DST (compression 7Z, TAR.GZ, ARC, RAR, AZW4, ZIP, LHA)
- Total pages original book: 148
- Includes a PDF summary of 12 pages
- Duration of the summary (audio): 8M29S (2.4 MB)
- Description or summary of the audiobook: Right now, all over the world, piano students are wasting precious practice time. And piano teachers are straining valuable vocal chords telling them to practice more. It's time to reexamine this setup, and cure the underlying piano practice ailments.The Piano Practice Physician's Handbook takes a fresh look at how piano teachers teach practice skills. These 32 piano student ailments and their cures open up new ways of thinking about piano practice problems. With this straight-forward and practical guide piano teachers can get their students practicing more effectively, making faster progress, and having more fun!
- Other categories, genre or collection: Keyboard Instruments, Teaching Of A Specific Subject
- Download servers: Torrent, Dropbox, Nullupload.com, Rapidgator.net, FileServe, Microsoft OneDrive, ExtraTorrent, 4Shared, Google Drive, Uploaded. Compressed in 7Z, TAR.GZ, ARC, RAR, AZW4, ZIP, LHA
- Format: Paperback
- Approximate value: 12.84 USD
- Dimensions: 127x203x8mm
- Weight: 154g
- Printed by: Not Available
- Published in: Not Available
-
The Handbook of Gestalt Play Therapy: Practical Guidelines for Child Therapists
Rinda Blom
248 Pages
-
101 Language Games for Children: Fun and Learning With Words, Stories and Poems
Paul Rooyackers
160 Pages
-
Socratic Circles: Fostering Critical and Creative Thinking in Middle and High School
Matt Copeland
176 Pages
-
Cambridge Handbooks for Language Teachers: The Standby Book: Activities for the Language Classroom
Seth Lindstromberg
262 Pages
-
Financial Vipers of Venice: Alchemical Money, Magical Physics, and Banking in the Middle Ages and Renaissance
Joseph P. Farrell
240 Pages